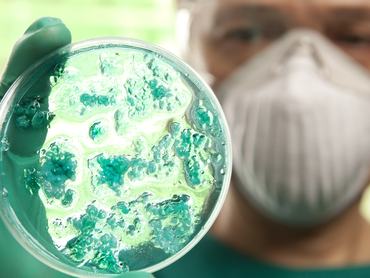

Elfogadták Békéscsaba idei költségvetését
Elfogadta a békéscsabai önkormányzat idei költségvetését a közgyűlés csütörtöki ülésén. Az elmúlt hónapokban látszó félmilliárd forintos hiányt egyebek mellett az önként vállalat feladatokra fordított kiadások csökkentésével, vagyonértékesítésből, valamint újabb hitel felvételével fedeznék.